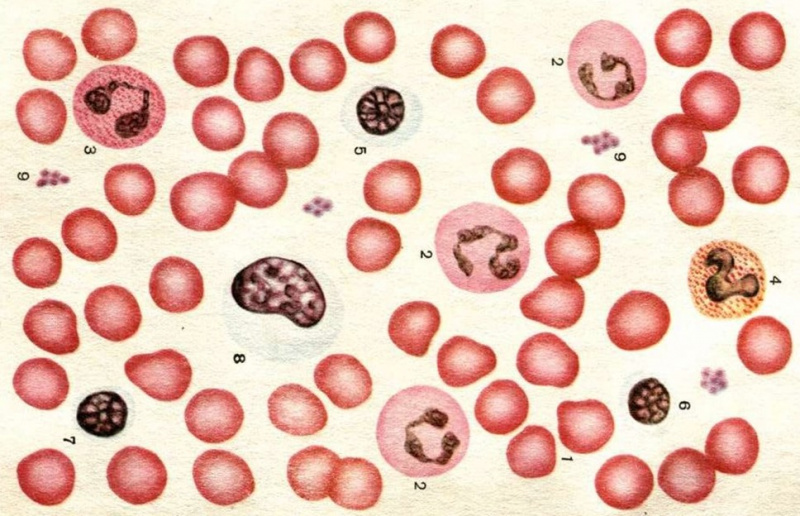

Внутрішнє середовище організму людини. Кров.

Відносна сталість складу та властивостей внутрішнього середовища організму - це ...
Рідка сполучна тканина організму, що циркулює по замкненій системі судин і є складовою частиною внутрішнього середовища організму, - це ...

Оберіть основні складові крові.
Назвіть захисну реакцію крові, яка залежить від тромбоцитів.
Визначте складову крові за характеристикою: безбарвні клітини, мають ядро, утворюються в червоному кістковому мозку та лімфатичних вузлах; руйнуються в селезінці та місцях запалення.

Які компоненти входять до плазми крові?

Що є головною функцією лейкоцитів?
Аглютиногени А і В містяться у крові ... групи.

Виберіть ознаки еритроцитів людини.

Оберіть людей, які НЕ можуть бути донорами.
Резус-фактор – це...
Під час операції виникла потреба перелити кров реципієнту, який має IV (AB) групу крові та негативний резус-фактор (Rh-). Яка кров є найбільш безпечною для цієї людини?
Який хімічний елемент у складі гемоглобіну надає крові червоного забарвлення?
Як називають людину, яка добровільно віддає частину своєї крові для переливання іншим?

Створюйте онлайн-тести
для контролю знань і залучення учнів
до активної роботи у класі та вдома


















